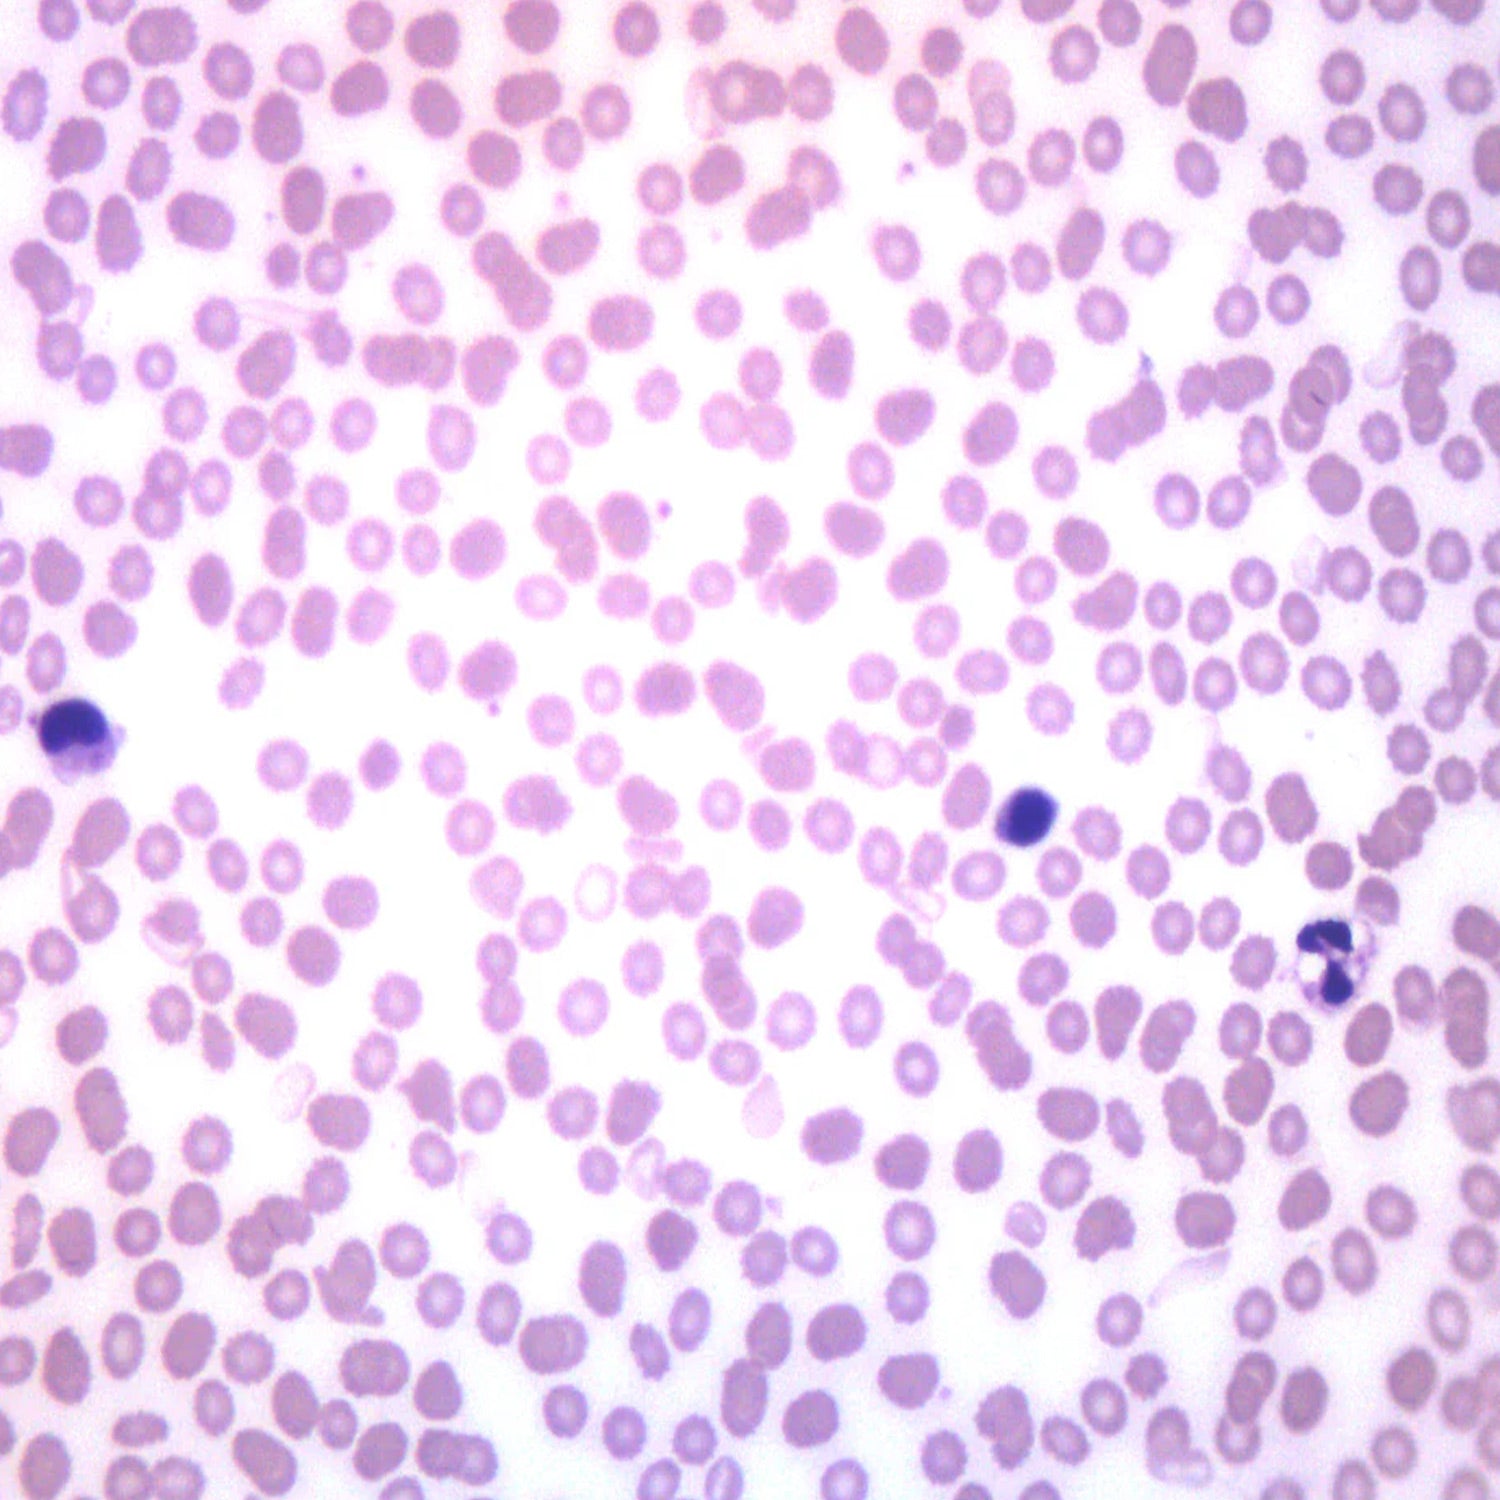

Collection:
Microscope Slides for Biology & Science Education
Nexera Scientific offers a wide selection of microscope slides designed to support hands-on science learning and research. Our collection includes prepared slides featuring plant, animal, and human specimens for biology and anatomy studies, as well as blank slides and cover slips for creating custom specimens. These microscope slides are perfect for K–12 classrooms, STEM programs, universities, and professional labs, helping students explore cell structures, tissues, and microscopic organisms with clarity and precision. Built for durability and optical quality, our slides enhance the learning experience and ensure accurate results. Whether you are teaching introductory biology, supporting advanced university courses, or building a complete lab kit, our microscope slides deliver trusted quality and educational value.
26 products